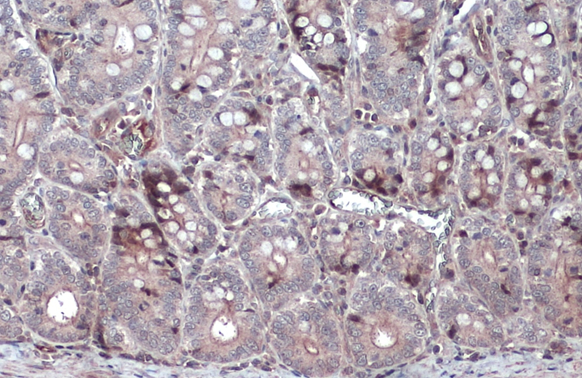
NFkB p105 antibody detects NFkB p105 protein at cytoplasm by immunohistochemical analysis. Sample: Paraffin-embedded dog intestine. NFkB p105 stained by NFkB p105 antibody (GTX110585) diluted at 1:500. Antigen Retrieval: Citrate buffer, pH 6.0, 15 min

NFkB p105 antibody detects secreted NFkB p105 protein by immunohistochemical analysis. Sample: Paraffin-embedded dog colon. NFkB p105 stained by NFkB p105 antibody (GTX110585) diluted at 1:500. Antigen Retrieval: Citrate buffer, pH 6.0, 15 min
NFkB p105 antibody
GTX110585
ApplicationsImmunoFluorescence, Western Blot, ChIP Chromatin ImmunoPrecipitation, ImmunoCytoChemistry, ImmunoHistoChemistry, ImmunoHistoChemistry Paraffin
Product group Antibodies
ReactivityCanine, Human, Mouse
TargetNFKB1
Overview
- SupplierGeneTex
- Product NameNFkB p105 antibody
- Delivery Days Customer9
- Application Supplier NoteWB: 1:500-1:3000. ICC/IF: 1:100-1:1000. IHC-P: 1:100-1:1000. *Optimal dilutions/concentrations should be determined by the researcher.Not tested in other applications.
- ApplicationsImmunoFluorescence, Western Blot, ChIP Chromatin ImmunoPrecipitation, ImmunoCytoChemistry, ImmunoHistoChemistry, ImmunoHistoChemistry Paraffin
- CertificationResearch Use Only
- ClonalityPolyclonal
- Concentration1 mg/ml
- ConjugateUnconjugated
- Gene ID4790
- Target nameNFKB1
- Target descriptionnuclear factor kappa B subunit 1
- Target synonymsCVID12, EBP-1, KBF1, NF-kB, NF-kB1, NF-kappa-B1, NF-kappaB, NF-kappabeta, NFKB-p105, NFKB-p50, NFkappaB, nuclear factor NF-kappa-B p105 subunit, DNA-binding factor KBF1, nuclear factor NF-kappa-B p50 subunit, nuclear factor kappa-B DNA binding subunit, nuclear factor of kappa light polypeptide gene enhancer in B-cells 1
- HostRabbit
- IsotypeIgG
- Protein IDP19838
- Protein NameNuclear factor NF-kappa-B p105 subunit
- Scientific DescriptionThis gene encodes a 105 kD protein which can undergo cotranslational processing by the 26S proteasome to produce a 50 kD protein. The 105 kD protein is a Rel protein-specific transcription inhibitor and the 50 kD protein is a DNA binding subunit of the NF-kappa-B (NFKB) protein complex. NFKB is a transcription regulator that is activated by various intra- and extra-cellular stimuli such as cytokines, oxidant-free radicals, ultraviolet irradiation, and bacterial or viral products. Activated NFKB translocates into the nucleus and stimulates the expression of genes involved in a wide variety of biological functions. Inappropriate activation of NFKB has been associated with a number of inflammatory diseases while persistent inhibition of NFKB leads to inappropriate immune cell development or delayed cell growth. [provided by RefSeq]
- ReactivityCanine, Human, Mouse
- Storage Instruction-20°C or -80°C,2°C to 8°C
- UNSPSC41116161

![Western blot of HeLa cell extract.? The membrane was blocked in 5% dry milk for 2 h.? After washing, a:1:1,000 dilution of the primary antibody was added to the membrane and incubated for 2 h.? Washes with buffer were performed 4 times for 5' each.? The western blot was incubated with secondary antibody (HRP Goat-a-Rabbit IgG [H&L]) diluted 1:2,000 for 1 h.?? Washes with TBS preceded color development.](https://www.genetex.com/upload/website/prouct_img/normal/GTX27549/GTX27549_20160330_WB_w_23060722_566.webp)

